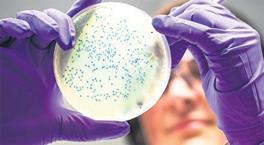
Koli basili can alıyor!

Yüzde 25 zam sınırı kaldırılıyor! Kira fiyatları nasıl etkilenecek? İşte detaylar...
29.06.2024 - 07:42 | Son Güncellenme:
Kira artışındaki yüzde 25 zam sınırı uygulaması 1 Temmuz’da sona eriyor. Peki bundan sonra ne olacak? Gayrimenkul ve Yatırım Uzmanı Hasan Ceran ve Avukat Arabulucu Dr. Umut Metin merak edilenleri cevapladı.

Milliyet.com.tr/ Mevcut uygulama ile kira artışlarında yapılan yüzde 25 artış sınırı uygulaması 1 Temmuz’da sona eriyor. Ev sahibi ve kiracılar arasındaki anlaşmazlıkların artacağını belirten uzmanlar bu durumun uzun süre devam edeceği, normale dönmenin zaman alacağı görüşünü paylaşıyor.
2022 yılında başlayan ve 2023 yılında da uzatılan kira artışında yüzde 25 zam sınırı yasası 1 Temmuz itibariyle sona eriyor. Geçen 2 yılda ev sahibi ve kiracı arasında önemli ölçüde anlaşmazlık yaşatan bu durumun tırmanacağını ifade eden Gayrimenkul ve Yatırım Uzmanı Hasan Ceran, uyuşmazlıkların ve hukuki davaların artacağı bilgisini verdi.
Ceran şu bilgileri verdi: “İş yerleri için bir değişiklik söz konusu değil ancak konutlarda ciddi bir kaos yaşanıyor ve durum uzun süre devam edecek gibi görünüyor. Yeni dönemde artış zamanı gelen kiracı TÜİK tarafından açıklanan TÜFE oranına göre zam yapmak durumunda. Sözleşmesinde farklı bir madde yoksa, TÜFE oranında diye belirtilmişse artışı da bu orana göre yapmak zorunda. Ancak ortada birtakım çözülemeyen durumlar çıkabiliyor; örneğin ev sahibi son iki yıldır kira arışında yüzde 25 oranını geçmediyse 10 bin liraya kiraya verdiği ve bugün yaklaşık 15 bin olan miktarı enflasyon oranının yüzde 65 açıklandığını farz edersek 25 bin TL civarında bir rakama çıkaracak. Benzer konutların kiralarının çok daha yüksek oluşunu gösterip bu rakamı düşük bulurken kiracı tarafında ise bir anda yüksek bir artış olarak görülecek. Uyuşmazlıklar artarken hukuki süreçler devreye girecek. Burada da hem ev sahiplerinin hem de kiracıların hukuki haklarını bilmesi büyük önem taşıyor.”
KİRA UYARLAMA DAVASI YA DA KİRA TESPİT DAVALARI ARTACAK
Yaşanan ve yaşanacak olan bu karmaşa içerisinde arabulucu, uzlaştırıcı gibi çözüm yolları ile sonuca gidilemediği takdirde kira uyarlama davası ya da kira tespit davalarının açılabileceği bilgisini veren Ceran bazı önemli hususlara da dikkat çekti:
“Yeni düzenleme ile 5 yılını doldurmayan kiracılar için yaşanan anlaşmazlıklarda kira tespit davası değil, kira uyarlama davası yoluna gidebilir. Sözleşme yapıldığı sırada taraflarca öngörülmeyen olağanüstü bir durum yaşanması halinde uyarlama davasına gidilebiliyor. Enflasyon, salgın hastalık, döviz kuru, deprem gibi durumlar buna dahildir. Bununla birlikte, kira kontratının 5 yılı doldurması halinde, yapılan artışı az bulan mülk sahibi ya da artışı yüksek bulan kiracı da kira tespit davası açabilir.
TÜFE oranının üzerinde bir zam söz konusu olduğunda haksız kira artış durumu nedeniyle sebepsiz zenginleşme hükümlerine göre istihkak davası açılabilir, ev sahibinin TÜFE oranında zam yapması ve kiracının ödeme yapmaması durumunda ise kiracının tahliyesi talep edilebileceği gibi icra yoluna da gidilebilir. Böyle bir durumda da borçluya alacak ve tahliye talepli ödeme emri gönderilir, kiracının 7 gün içinde itirazda bulunmaması halinde ve 30 gün içinde borcunu ödememesi durumunda icra müdürlüğü kanalı ile tahliyeye gidilir.”
HANGİ DURUMLARDA TAHLİYE GERÇEKLEŞİR?
Tahliye koşullarına da değinen Hasan Ceran, konut kirasının çevredekilere göre düşük kalması halinde kira uyarlaması davası açılmış ise ve yeni belirlenen kiranın kiracı tarafından kabul edilmediği durumda kiracının çıkartılabileceğini, kira süresi 11 yılı doldurdu ise ev sahibinin kiracı sözleşmesini yenilememe hakkına sahip olduğunu bildirdi. Bununla birlikte kira kontratında belirlenen maddelerden birinin ihlali, ev sahibinin birinci derece yakınının konut ihtiyacı, evin tadilata alınması ya da satılması halinde yeni malikin gereksinim sebebiyle tahliyesini istemesi, kiracının tahliye taahhüdü imzalaması, kira ödenmediği ve ihtarname çekilmesine rağmen 30 günlük ihtar süresinde ödeme yapılmaması, kiracının oturduğu konuta zarar veren davranışlar içinde olması gibi durumların da tahliye sebebi olabileceğini belirtti.
KİRADA YÜZDE 25 SINIRININ KALKMASI MEVCUT DAVALARA YANSIMAYACAK
Yüzde 25 kira zam sınırının kalkması ile ilgili açıklamalarda bulunan Avukat Arabulucu Umut Metin, ‘‘Mevcut kira tespit davalarının yüzde 25 düzenlemesi ile herhangi bir bağı bulunmamaktadır. 1 Temmuz sonrası yüzde 25 zam sınırlamasının kalkacağı bildirilmişti. Yeni dönemde TÜFE oranlarına göre zam yapılacaktır. Mülk sahipleri tarafından istenilen oran kadar zam yapılabilecek algısı olmamalı. 1 Temmuz sonrası yenilenecek kira sözleşmelerinde zam oranı son 12 ayın TÜFE rakamları baz alınarak yapılacaktır. Geçmiş 2 yılda yüzde 25 zam yapıldıysa yeni dönemde geçmiş 2 yıldaki farkları da TÜFE rakamlarına ekleyerek zam yapılamaz’’ dedi.
“YENİ KİRA SÖZLEŞMELERİ MAKSİMUM SON 12 YILLIK TÜFE ORTALAMASINA GÖRE YAPILIR”
Kira zam oranlarının son 12 aylık enflasyon ortalamasının üstünde olamayacağını belirten Metin, ‘‘Yeni kira sözleşmeleri maksimum son 12 yıllık TÜFE ortalamasına göre yapılır. Sözleşmelerde farklı zam oranlarında anlaşılmış olabilir. Böyle durumlarda da sözleşmedeki zam oranı TÜFE’nin altındaysa anlaşılan sözleşmedeki oran geçerlidir. Eğer sözleşmedeki oran TÜFE’nin üstüne çıkmışsa TÜFE oranları geçerlidir’’ diye konuştu.
“GEÇMİŞE DÖNÜK KİRA FARKI MÜLK SAHİBİNE ÖDENİR”
Metin, kira tespit davalarında hakimin hükmettiği kira bedelinin geçmişe dönük farkının kiracı tarafından mülk sahibine ödeneceğini söyledi. Metin, ‘‘Kira tespit davaları olduğunda davalar uzun sürebiliyor. Kira tespit davaları, hakim tarafından mülkün emsallerine göre fiyatının belirlenmesidir. Taraflar dava öncesi arabulucu ile anlaşamadıysa dava sürecinde hakimin kararı beklenir. Dava sürecinde kira düşük ise hakim daha yüksek bir kiraya hükmettiyse geçmişe dönük kirayı kiracı ödemek zorundadır. Dava ne kadar uzun sürdüyse hakimin hükmettiği kira ile dava öncesi kira arasındaki fark kiracı tarafından faizsiz olarak öder. Toplumumuzda empati yaparak dava öncesi sorunları çözmek bir fırsattır. Arabuluculuk bu fırsatları mümkün kılıyor, toplumsal barışa hizmet ediyor’’ şeklinde konuştu.